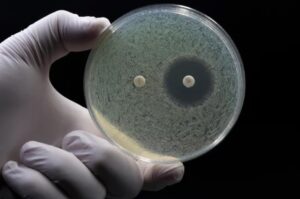

17.02.2026 Скопље
Већина грађана Сједињених Америчких Држава током живота страствену љубав доживи у просеку два пута, док 14 одсто никада није имало такво искуство, показују резултати истраживања које је спровео амерички Институт Кинси. У студији је анкетирано 10.036 самаца старости од 18 до 99 година широм САД, којима је постављено питање колико су пута у животу били страствено заљубљени, а просечан одговор износио је 2,05 пута, објављено је у научном часопису “Interpersona: An International Journal on Personal Relationships”.
Према резултатима, 14 одсто испитаника никада није искусило страствену љубав, 28 одсто навело је да им се то догодило једном, 30 одсто два пута, 17 одсто три пута, док је 11 одсто изјавило да су били страствено заљубљени четири или више пута.
“Људи стално говоре о заљубљивању, али ово је прва студија која је заиста поставила питање колико се то пута догађа током живота. За већину људи, страствена љубав је искуство које се деси само неколико пута”, изјавила је водећа ауторка истраживања и научница на Институту Кинзи Аманда Геселман.
Истраживачи су страствену љубав дефинисали кроз два кључна аспекта: појачану физиолошку побуђеност, попут “лептирића у стомаку”, влажних дланова и убрзаног пулса, као и снажну психолошку потребу да се буде у близини вољене особе. Искуства страствене љубави била су слична међу хетеросексуалним, геј, лезбејским и бисексуалним испитаницима. Старији учесници пријавили су нешто већи број таквих искустава него млађи, што указује да се страствена љубав може јавити и у каснијем животном добу. Мушкарци су у просеку пријавили благо већи број искустава него жене, а разлика је била израженија код хетеросексуалних мушкараца у односу на хетеросексуалне жене. Ипак, истраживачи истичу да су те разлике мале и да страствена љубав представља заједничко људско искуство.
Подаци Института Кинзи, прикупљени у сарадњи са платформом за упознавање “Match”, показују и да 60 одсто самаца у САД себе сматра врло романтичним, док већина верује у љубав на први поглед и у судбину. Истовремено, 51 одсто испитаника наводи да осећа већи притисак да пронађе љубав него претходне генерације, а 73 одсто сматра да романтични садржаји у медијима постављају нереална очекивања када је реч о везама.
Аутори оцењују да резултати помажу бољем разумевању романтичних очекивања и указују на то да, упркос снажној присутности идеје о великој љубави, страствена заљубљеност за већину људи остаје релативно ретко искуство.
Припремила А.Ђ.